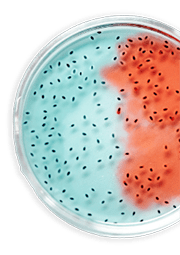

Research & Development
We believe a critical component of the ongoing success and sustainable growth of our branded products business is our ability to develop and introduce new products into our portfolio.
We ensure each of our products passes through a strictly monitored pipeline, from product identification, through development, manufacturing, and finally to launch.